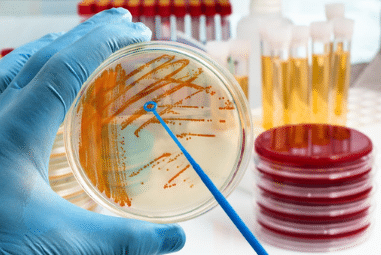
Cell Culture Products

Description
The overall chromatography columns & supplies includes 9 functionally different types of products. This market assessment includes the following market briefs:
- GC Columns
- GC Supplies
- Analytical HPLC Columns
- Preparative HPLC Columns
- HPLC Supplies
- SFC Columns
- Ion Chromatography Columns
- Flash Cartridges
- LPLC Columns
This section is directly extracted from the The Global Laboratory Consumables Market, published September 2020.
The report is designed for general management, product managers and marketing executives in the laboratory instrumentation consumables industry. Those involved in a particular technology or product line can obtain up-to-date statistics in their areas of interest, and gain insights into related or tangential areas. Those concerned with more than one segment, or the whole industry, can use the report to evaluate markets, the competitive landscape, or identify opportunities and acquisition targets.
A strategy for consumables must take in geographic market compositions, consumable-driven growth rates, even new competitors in many markets. SDI’s report saves time by making these estimations already. Proper market adjustments for the pandemic and lab closures and openings have already been factored in.
For information on the instruments these consumables run on, please see our other annual report: The 2020 Global Assessment Report for Life Science and Analytical Instrumentation.